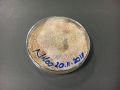

Second Experience of Physarum with Medium of Potato and Oat
I made a new sample with a new medium. Parallel to the samples that I use for the experiment I started to use this new Medium to grow the specimen (to have live healthy samples to experiment), I started from the formula that Fernanda Caicedo gets to in her previous experiments, and I altered for my special use. [1], EIGHTH EXPERIMENT.
- Medium: 20.11.2018
- 100 ml water
- 12 gr cooked potatoes
- 12 gt oat flakes
- (mix together)
- 2 gr Agar
- Mix all together and boiled for 2 minutes
- Medium: 07.12.2018
- 100 ml water
- 12 gr cooked potatoes
- 2 gr Agar
- Mix all together and boiled for 2 minutes
- Medium: 07.12.2018
- 100 ml water
- 12 gt oat flakes
- 2 gr Agar
- Mix all together and boiled for 2 minutes
- After this Experiment, I made an other Medium with more than wasser
- Medium: 11.12.2018
- 150 ml water
- 12 gr cooked potatoes
- 12 gt oat flakes
- (mix together, filter)
- 2 gr Agar
- Mix all together and boiled for 2 minutes